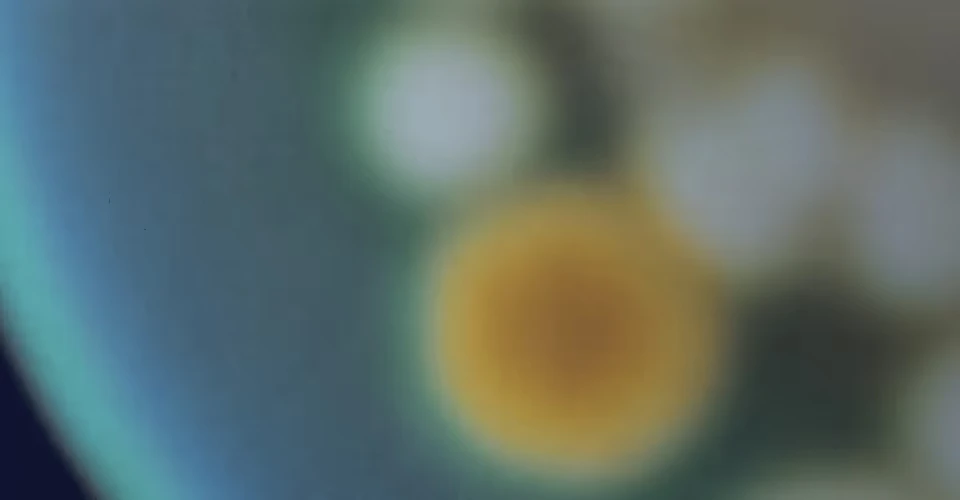
Quiz promo background

Shop All
Bundle & Save
Our most-loved products, paired for seamless support and smart savings. Cannot be combined with additional discounts.
Our probiotic duo with daily oral capsules & targeted suppositories.
Get advanced insights and daily support with our test & probiotic.
Test twice with Evvy to track progress, catch imbalances, and save $60 when you bundle
Get to the root cause of your vaginal and urinary symptoms
Evvy Tests
Comprehensive vaginal health and UTI insights, all from home.
Get advanced insights into symptoms, fertility, and other health outcomes. Prelim results in 1-3 days.
Comprehensive at-home urine test for key uropathogens & antibiotic resistance — get the right treatment, the first time.
Advanced Probiotics
For daily microbiome maintenance.
Advanced 3-in-1 microbiome support for gut, urinary, and vaginal health
Rebuild healthy bacteria & prevent symptoms
Clinical Care & Rx Symptom Relief
Explore prescription programs and products for vaginal health — all guided by licensed providers.
Manage symptoms & vaginal pH
Quickly calm itching & irritation
Break the cycle of BV recurrence
Gently soothe dryness & irritation
Relieve dryness, hormone-free
Relieves dryness in menopause
Rebuild and protect your vaginal microbiome
More from Evvy
Our limited-edition coffee table book features 100 shocking truths about gender disparities in healthcare research, access, and treatment.
Redeemable on Evvy tests, probiotics & more